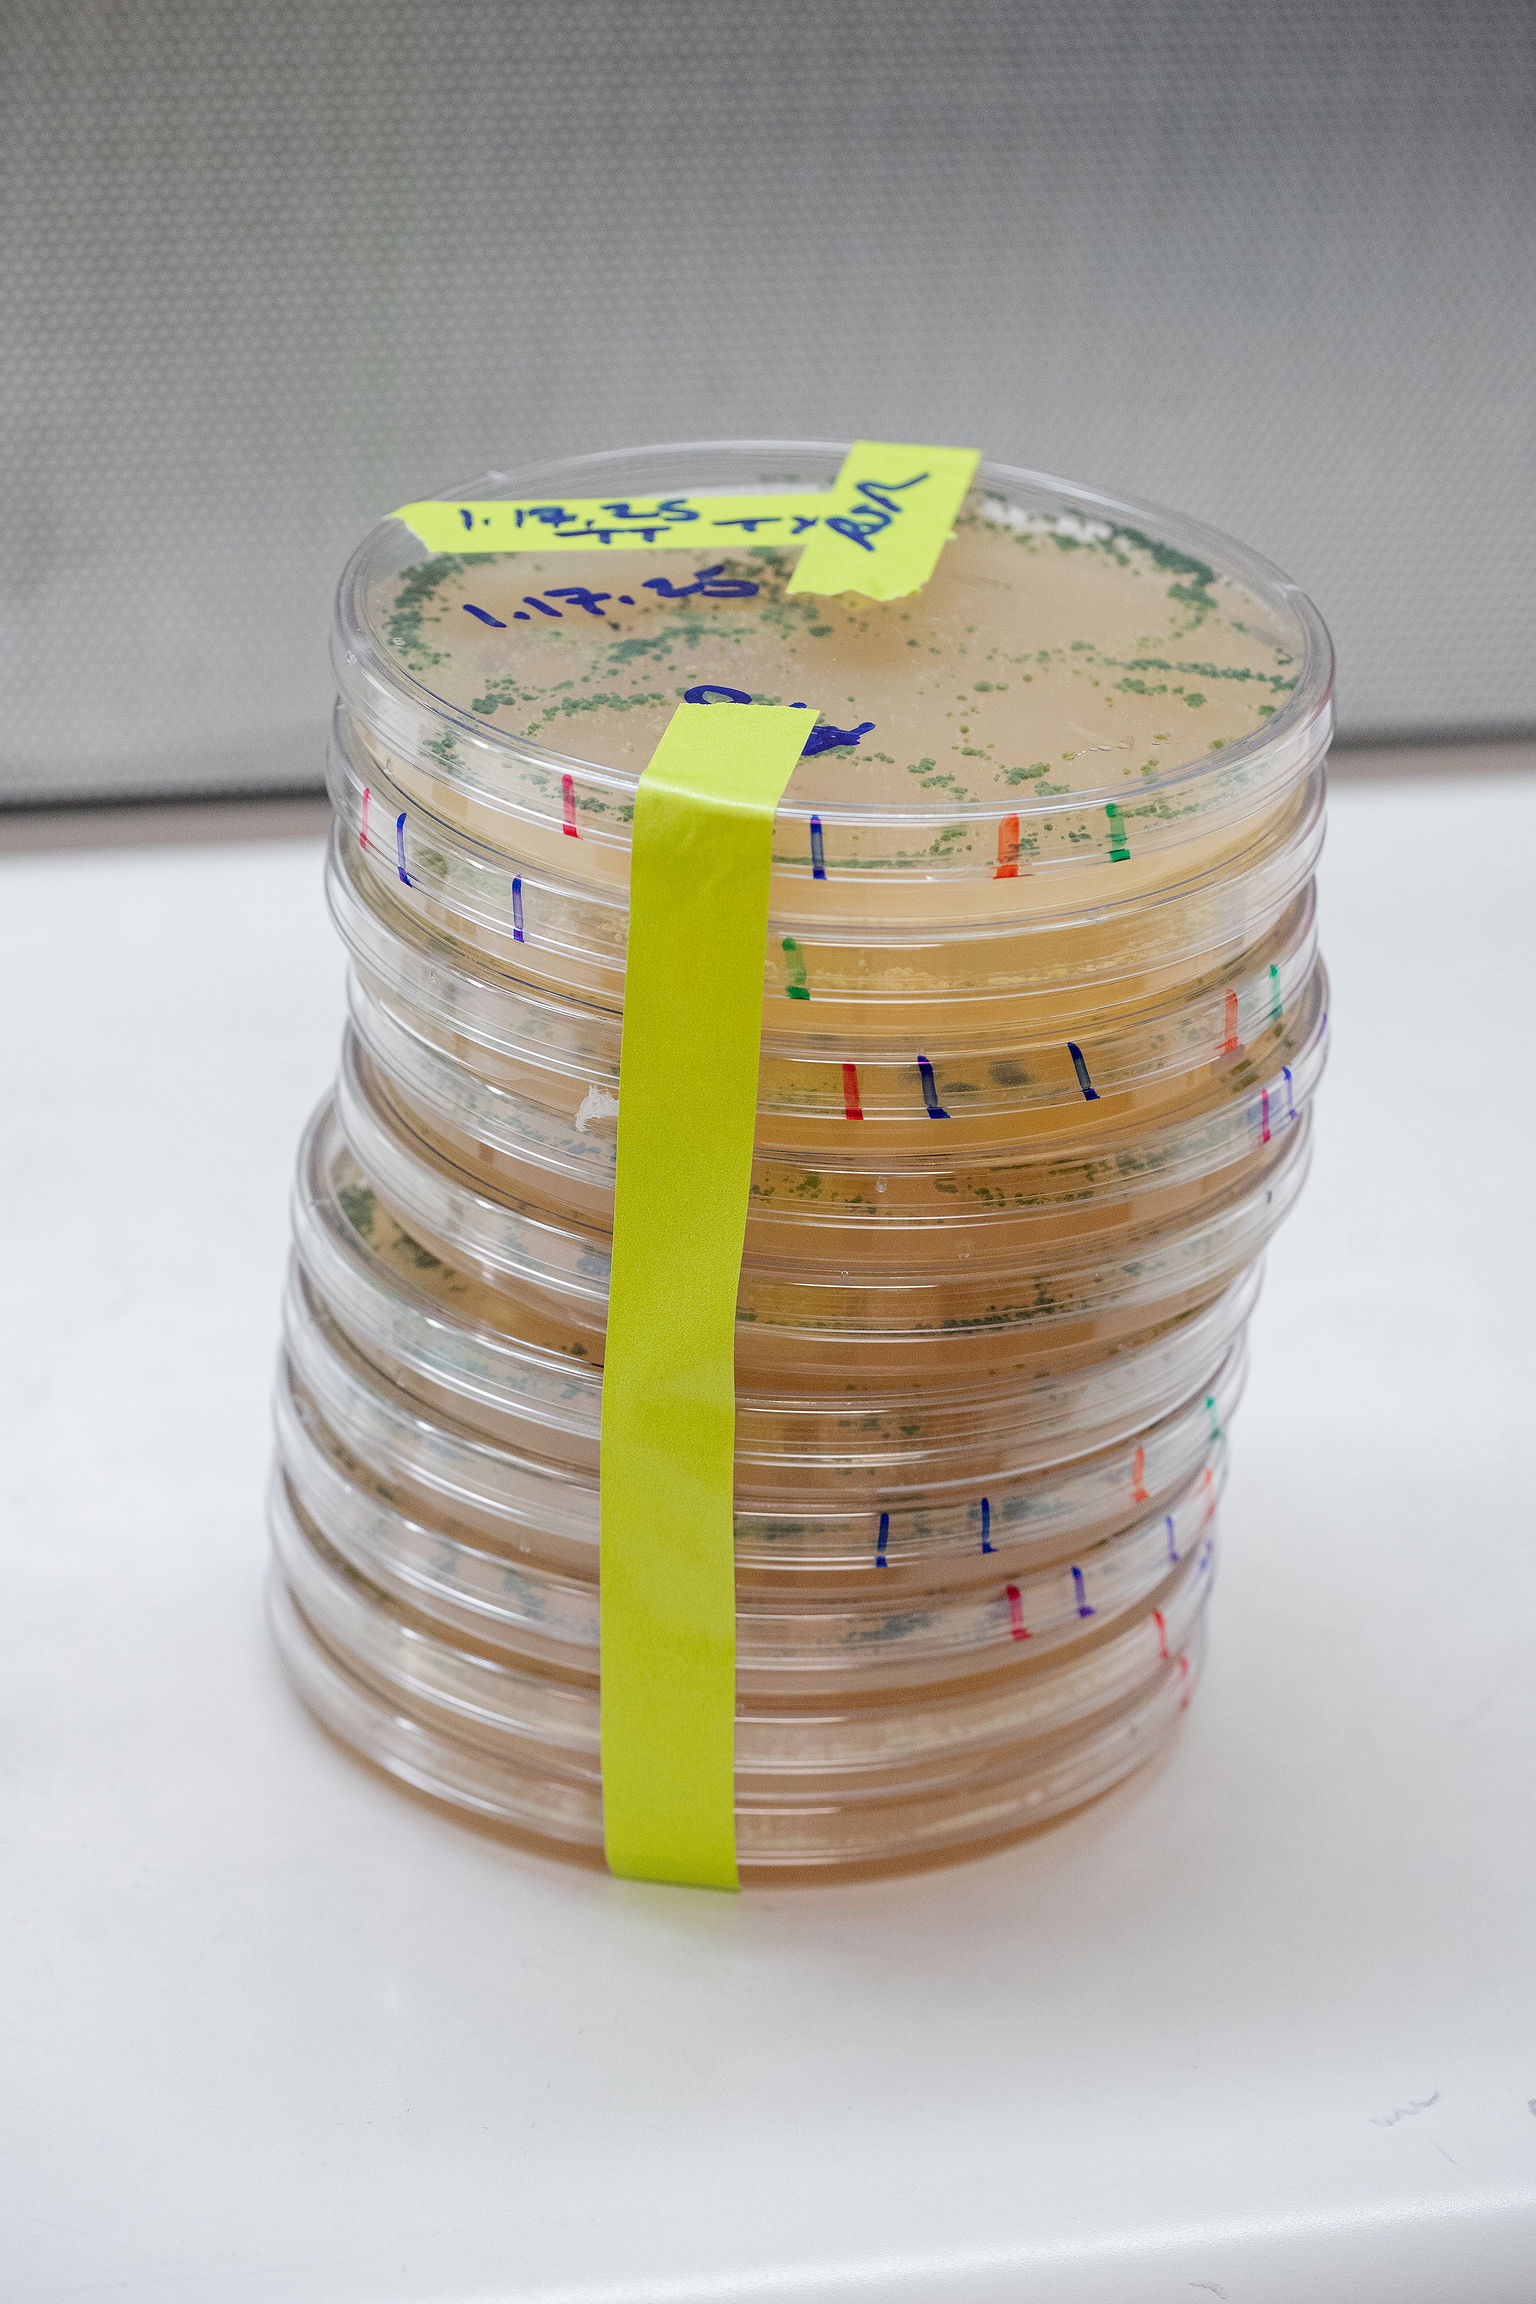

A once-dismissed discovery in Yellowstone’s geothermal soils is now helping farmers worldwide fight drought, boost yields, and reduce dependence on chemical fertilizers.
SEATTLE, U.S.A. — Russell “Rusty” Rodriguez didn’t expect to find a key to climate resilience in the superheated soils of Yellowstone National Park. But in 1999, while studying how plants survive in extreme conditions, he and his colleagues Regina Redman and Joan Henson stumbled upon something that could transform global agriculture. They thought their discovery would be celebrated. Instead, they were met with resistance from many scientists.
At the time, Rodriguez was part of the faculty at University of California, Riverside, focusing his research on plant pathology—studying fungal pathogens and what differentiates them from beneficial fungi. He was curious to find out how plants adapted to climate stressors, particularly heat and drought.

Drought pressure causes stunted growth in plants, as well as loss in crop yield and reduced seed germination. Drought has become the biggest concern in terms of food security, putting millions of people at risk of hunger. One quarter of the world’s crops are grown in areas where water supplies are highly stressed and unreliable. Rice, wheat, and corn, which provide more than half the world’s food calories, are particularly vulnerable. Maize crop yields have been projected to decline by 24% by 2030, thanks to climate change impacts.
Since the 1960s, there has been an enormous effort worldwide to generate drought-resilient crops, says Rodriguez, from trying to breed drought-adapted plants with crop plants, to genetic engineering. “And that has been largely unsuccessful,” he adds. “There are no commercially available heat- or drought- tolerant crops—anywhere.”
The approach, Rodriguez says, was a bit naive. “They were focused on the plant being in control of its own destiny.”
It has been common knowledge for a long time that plants are colonized with microbes—just like us. Mycorrhizal fungi are the most well-known; they form a symbiotic relationship with the plant’s roots and grow into the soil, transferring nutrients and water to the plants.
But not all plant-supporting fungi live in the soil. Some, called endophytes, reside entirely within the plant, weaving themselves between its cells. Unlike their more famous counterparts—mycorrhizal fungi, which extend root net- works—endophytes work from the inside out, influencing how plants respond to their environment.

“We knew that plants can adapt to stressors,” Rodriguez explains. “There are desert plants, cold plants, there are all sorts of stress-tolerant plants. So my colleagues and I decided to start asking questions about how plants adapt.”
Very few scientists, says Rodriguez, have asked this question of whether plants are in charge of their own destinies. “Being a microbiologist, I’m more biased on that front, and we’d already learned so much about how microbes can influence plants, so we went out and started looking at whether microbes influenced how plants adapt to stressors.”
Back in the late 1990s, Rodriguez and his colleagues went out to Yellowstone National Park, where in geothermal areas there are places where plants thrive despite the soil being very hot, sometimes reaching up to 65.5°C (150°F). “We started asking questions about how they survive.”
We realized that this could be an answer for mitigating the impacts of climate change.
Eventually, by running field tests for more than a year, the scientists found that the plants were colonized by endophytes—and it was these endophytes, living inside the plants, that were the reason why these plants could survive under such intense conditions. The moment of discovery is seared in Rodriguez’s mind. “I’ll never forget it,” he says. “We were like, ‘Wait a minute, wait a minute, let’s check the maps and make sure we’re seeing this right.’”
They were seeing it right. “Turns out that these fungi were responsible for the plants ’ ability to tolerate the higher temperatures,” says Rodriguez. “We realized that this could be an answer for mitigating the impacts of climate change. These fungi have a profound impact on plants.”

The scientists published their discovery in 2002. But the paper was not well received. “At the time I thought, ‘oh, you make a great discovery and people will embrace it’,” Rodriguez remembers. “But we got a lot of heat from the scientific community. I was yelled at in meetings. Our discovery did not fit into the paradigm of ecology and plant biology, and after that we had difficulties getting grants and getting our papers published.”
For the next decade, Rodriguez and his team conducted intensive lab research to support their discovery, including growing the plants in hot conditions without the endophytes (they died). “But when we put the plants back together with the endophytes, they could survive these 150F temperatures again,” Rodriguez says. “The symbiosis between the plant and the endophytes was clearly responsible for their heat tolerance.”

Through experimenting with different plants from different stressful environments, such as salinity and cold, Rodriguez and his colleagues found that the plants needed the specific fungus that was indigenous to the soil the plants came from to survive. In fact, it’s a virus in the fungus that enables heat tolerance—it’s a three-way symbiosis.
Years of academic scepticism pushed Rodriguez in a new direction. If he couldn’t convince the scientific establishment, he’d take his research directly to the field. In 2012, he launched Symbiogenics, a nonprofit focused on applying his findings to real-world agricultural challenges. Around the same time, his wife, geneticist Regina Redman, was developing a startup, Adaptive Symbiotic Technologies (AST), to create climate-resilient plant treatments that harnessed beneficial fungi. Their work aligned perfectly—so they joined forces.

Eventually, AST landed enough funding to bring on staff and focus on developing a product, opening a laboratory in Seattle, Washington. They began field trials on land across the globe ranging from small plots to 100 acres, and have performed more than 1,000 trials since 2012. Crops were sprayed with a liquid form of the fungi and the results were significant, Rodriguez says; irrespective of climate zone and soil type, when the fungi were applied to plants, crop yields increased. During low-stress growing seasons, treated seeds increased crop yields by an average of 3-5%, during high-stress growing seasons, there was an increase of up to 50%.
In 2017, they commercialized their first product, BioEnsure, a fungal inoculant liquid that can be sprayed directly onto plants, either at seed stage, or when they’re fully grown. They began a partnership with an independent seed company to conduct large-scale experiments on corn and soy fields that had been damaged by heat and drought. Within just a matter of days, the plants began recovering. Not only that, but the company ended up with large yield differences between the control crops that weren’t treated and the crops that were.
“They started buying from us the next year, and now they put our product on all their seeds,” says Rodriguez.

Since 2017, the year AST went commercial, BioEnsure has been sprayed on 12 million acres in the U.S., primarily soy and corn. It’s been a difficult arena to expand into, though, due to the dynamics of large seed companies, and AST mostly takes on smaller agricultural distributors.
But while AST faces roadblocks in the U.S., its potential is being recognized abroad. In India and Africa, smallholder farmers—who bear the brunt of climate change—are already seeing yield increases of up to 60% using AST’s treatments, the company reports. According to the farmers, the quality of the yield also improved.
AST now has four products for sale, including the fungal inoculant liquid BioEnsure and BioEnsureFP—a powder version of the original.

After creating the fungal inoculant products, the AST team wanted to see if they could boost the yields that BioEnsure produced by developing a bacterial product that would act as a fertilizer, fixing atmospheric nitrogen—an essential plant nutrient—and making soil minerals such as potassium and phosphorus easier for the plant to absorb.
They came up with BioTango, a bacterial inoculant powder, and BioIQ, a blend of BioEnsure and BioTango, in powder form. All products are organic and have been found to increase crop yield and yield quality, as well as improved seed germination. AST has introduced BioTango in Ghana and found it replaced at least 50% of chemical fertilizers used by farmers. Tests on corn in Indiana showed using BioIQ increased yield by up to 15.3%, and in soy crop testing in Michigan, yield increase was 12%.
There is no shortage of farmers who would welcome yield increases like these. There are an estimated 570 million farms on the planet, and about 80% of them are operated by small landowners. So the question, Rodriguez says, becomes: “How are you going to reach 456 million farmers?”

AST doesn’t have the resources to hire a big sales team to reach that many farmers. Instead, they develop products that fit into the existing supply chain. Rather than individual farmers, they work with distributors who sell their product to farms. And they’ve worked to boost their production system so they have the capacity to produce 30 million acres worth of product each year.
This year they are beginning to work with farms in Canada, as well as branching into the country of Jordan. With further expansion into the Middle East and Africa on the horizon, Rodriguez is hoping that these humble fungi could bring about global change.










